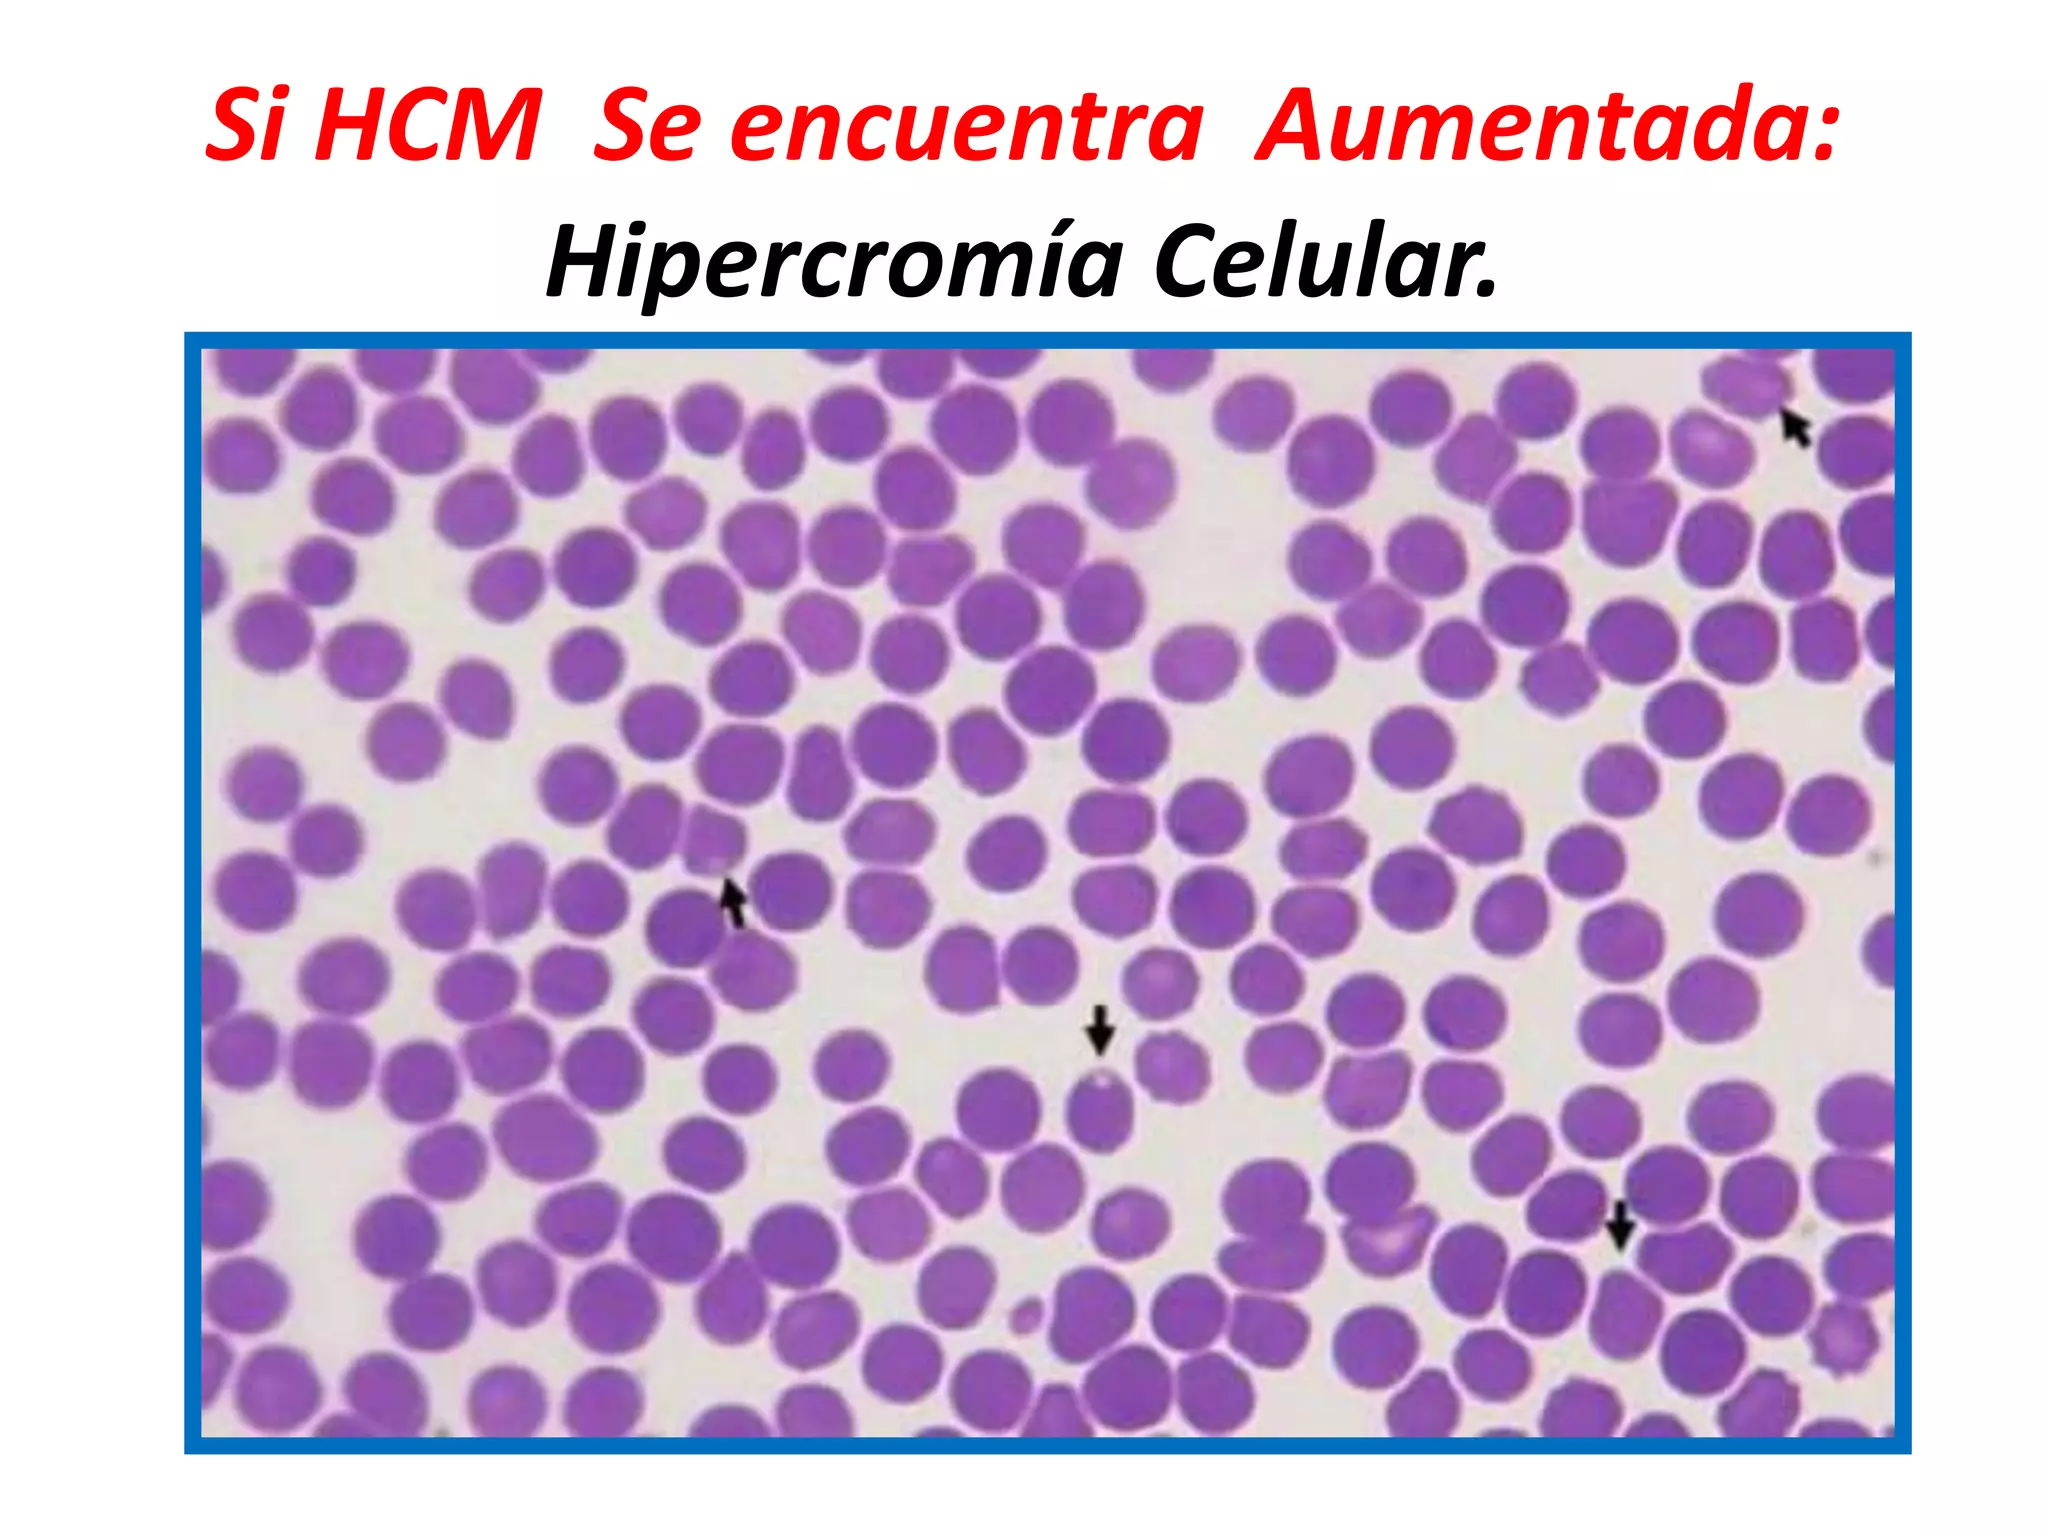
Si HCM Se encuentra Aumentada:
Hipercromía Celular.

Este documento resume los parámetros fundamentales de una biometría hemática completa (BHC), incluyendo los valores normales y la interpretación clínica de los recuentos de eritrocitos, hemoglobina, hematocrito, índices eritrocitarios, velocidad de sedimentación globular y reticulocitos. Además, explica las posibles causas de alteraciones en estos parámetros.